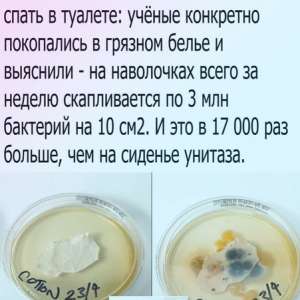
Image

2 годы назад
«Покойся с миром, родной, этого мы нашим врагам точно не забудем»
➡Мнения: https://russian.rt.com/opi...
➡Мнения: https://russian.rt.com/opi...
Показать больше
2 годы назад
В Госдуме ответили на обвинения премьер-министра Японии в создании Россией ядерной угрозы
➡Подробнее: https://russian.rt.com/wor...
➡Подробнее: https://russian.rt.com/wor...
Показать больше
2 годы назад
2 годы назад
В России предложили ввести курсы вождения электросамокатов для курьеров
➡Подробнее: https://russian.rt.com/rus...
➡Подробнее: https://russian.rt.com/rus...
Показать больше
При финансовой поддержке
Memes Admin
5 мс. назад